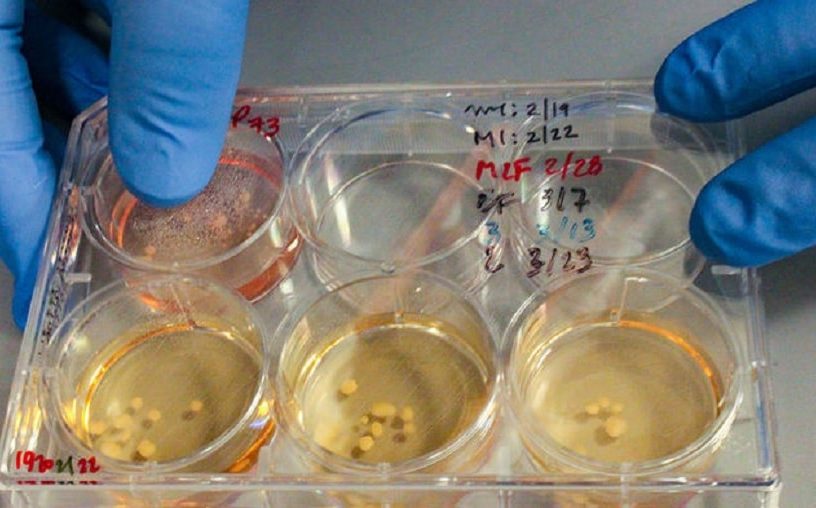

La reconstitution en 3D du visage du général romain montre les traits d’un homme peu charmant, avec une forme de...
Le plus ancien
Histoire
Le monde, ou plutôt l’Internet, se tord de rire depuis la dernière trouvaille satellite insolite. Et nous sommes obligés d’avouer que,...
Il y a plusieurs dizaines de milliers d’années, Néandertal et Homo sapiens ont partagé la Terre. Puis, il y a environ 40’000 ans, Néandertal s’est éteint. Plusieurs hypothèses ont été avancées pour expliquer cette disparition et, bien que de nombreuses découvertes en paléoanthropologie aient été réalisées, les causes de l’extinction...
Jusqu’où est arrivée la « Grandeur de la France » ? Nous avons souvent entendu parler de cette « grandeur », mais jusqu’où ce...
Un véritable problème technologique d’une envergure nationale à cause d’un seul homme ? Mais de qui pourrait-il s’agir ? Son...
Cette célèbre photographie n’est pas un fake, elle a maintenant 85 ans et comporte 7 petites particularités qui valent la peine d’être racontées. Lunch atop a Skyscraper, signifiant littéralement « déjeuner au sommet d’un gratte-ciel » (en anglais), est un cliché pris pendant la construction du RCA Building (maintenant appelé Comcast building) à New York,...
Au cœur de la ville de Cologne, en Allemagne, des travaux de construction ont mené à la découverte de la...
Des milliers d’années avant l’arrivée des chats dans les foyers modernes d’aujourd’hui, ces animaux ont parcouru des continents avec des...
L’art et la culture sont les fondations de toute société humaine. Chaque peuple construit et rayonne son identité en partie grâce à son patrimoine culturel, et celui-ci possède une valeur inestimable. Les conséquences sont dès lors tragiques lorsque ces trésors disparaissent. L’incendie qui a ravagé le Musée National du Brésil,...
En 1929, Anne Morrow Lindbergh et son mari Charles ont survolé la péninsule du Yucatán. Lors du survol, Anne a...
Le patrimoine artistique de l’humanité vient de franchir une nouvelle étape historique. Dans une paroi de grotte au fond des...
Si quelqu’un vous demandait quelle a été la pire année de l’histoire humaine, que répondriez-vous ? Par exemple, l’an 1347 a été assez terrible : c’est l’année durant laquelle la peste noire a frappé l’Europe. Toutes les années de l’Holocauste, entre 1941 et 1945 sont également effroyables. De nombreux autres exemples...